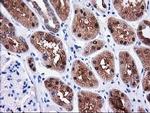
SULT1C2 Antibody in Immunohistochemistry (Paraffin) (IHC (P))

Search
OriGene
SULT1C2 Monoclonal Antibody (OTI4G1), TrueMAB™
{{$productOrderCtrl.translations['antibody.pdp.commerceCard.promotion.promotions']}}
{{$productOrderCtrl.translations['antibody.pdp.commerceCard.promotion.viewpromo']}}
{{$productOrderCtrl.translations['antibody.pdp.commerceCard.promotion.promocode']}}: {{promo.promoCode}} {{promo.promoTitle}} {{promo.promoDescription}}. {{$productOrderCtrl.translations['antibody.pdp.commerceCard.promotion.learnmore']}}
产品信息
CF502554
种属反应
宿主/亚型
分类
类型
克隆号
抗原
偶联物
形式
浓度
纯化类型
保存液
内含物
保存条件
运输条件
产品详细信息
For reconstitution, we recommend adding 100 µL distilled water to a final antibody concentration of about 1 mg/mL. To use this carrier-free antibody for conjugation experiments, we strongly recommend performing another round of desalting. (Zeba Spin Desalting Columns, 7KMWCO, 0.5 mL, Product # 89882)
靶标信息
Sulfotransferase enzymes catalyze the sulfate conjugation of many hormones, neurotransmitters, drugs, and xenobiotic compounds. These cytosolic enzymes are different in their tissue distributions and substrate specificities. The gene structure (number and length of exons) is similar among family members. SULT1C2 belongs to the SULT1 subfamily, responsible for transferring a sulfo moiety from PAPS to phenol-containing compounds. SULT1C2 belongs to a SULT subfamily that shows specificity for hydroxyarylamines. SULT1C2 catalyzes the sulfonation of p-nitrophenol and N-hydroxy-2-acetylaminofluorene, but not dopamine.
仅用于科研。不用于诊断过程。未经明确授权不得转售。
篇参考文献 (0)
生物信息学
蛋白别名: 1C member 4; humSULTC2; MGC149521; MGC34422; ST1C2; Sulfotransferase 1C1; Sulfotransferase 1C2; sulfotransferase family, cytosolic, 1C, member 1; sulfotransferase family, cytosolic, 1C, member 2; SULT1C#1
基因别名: humSULTC2; ST1C1; ST1C2; SULT1C1; SULT1C2
UniProt ID: (Human) O00338
Entrez Gene ID: (Human) 6819